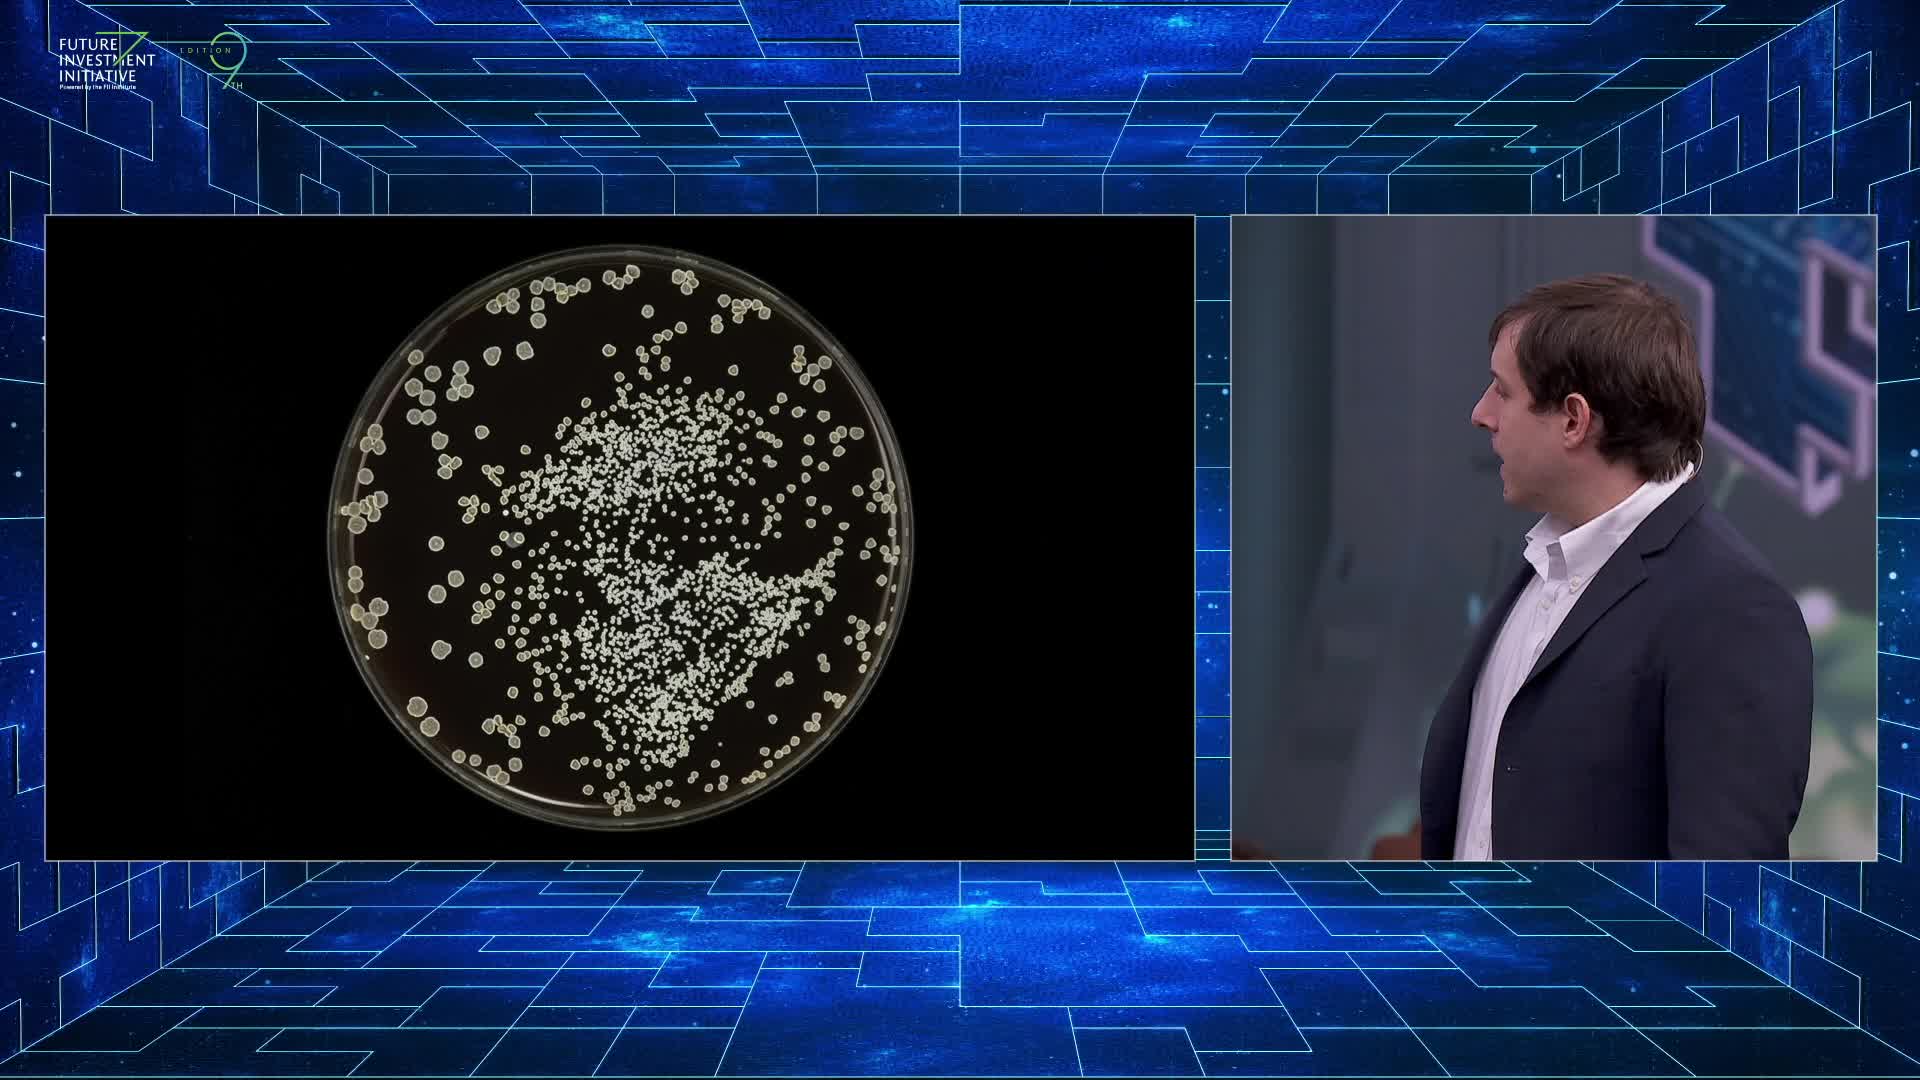
IS THE BRAIN THE FINAL FRONTIER?

Ferit Şahenk - Chairman, DOGUS Group
AI & DIGITAL TRANSFORMATION IN THE ASSET MANAGEMENT INDUSTRY
Majid Mufti - CEO, NEOM Investment Fund
FIRST BOARD OF CHANGEMAKERS: GEOECONOMICS
Bernard Mensah - President, Bank of America
The Debate - FII Innovators Pitch
Amanda Staveley - Owner, PCP Capital Partners
RISK OR REVOLUTION, A CONVERSATION WITH MOONSHOT CEOS, MARC LORE & SAM NAZARIAN
Ibrahim Sagna - Executive Chairman, Silverbacks Holdings
Dr Adah Almutairi - University of California
INTRODUCTORY SPEECH BY H.E. YASIR AL-RUMAYYAN
IS GREEN SHORING THE FUTURE OF A TRULY GLOBAL BUSINESS?
TITAN OF INVESTMENT
TITAN OF INDUSTRY
WHAT NEW TECHNOLOGIES CAN SECURE ENERGY FOR THE NEXT CENTURY?
UNLOCKING MENA'S CAPITAL CONTINUUM: PART II. LOCAL MARKET DYNAMICS & GLOBAL VALUATION ALIGNMENT, POWERED BY INSEAD & JADA FUND OF FUNDS
Peter Y Levin - Co-Founder & Managing Director, Griffin Gaming Partners
ANNOUNCEMENT & SIGNING CEREMONY
Michael Dyke - CEO, New Murabba
Eric Schmidt - Co-founder with his wife, Wendy, Schmidt Sciences; Former CEO & Chairman, Google, KBE
FUTURE OF ENERGY: WHAT WILL ACCELERATE THE ENERGY TRANSITION CURVE?
Marco Mejia - CEO, King Salman Airport
HOW CAN AFRICA LEAD THE FIGHT AGAINST FOOD INSECURITY?
WHICH TECHNOLOGIES WILL DEFINE THE FUTURE OF FOOD?
Robert Simonds - Founder & CEO, STX Entertainment
BRIDGING BORDERS: WHAT ARE LEADERS’ LESSONS TO THE NEXT GENERATION?
Joerg Ambrosius - President, Investment Services, State Street
FII8 Highlights
UNLOCKING MENA'S CAPITAL CONTINUUM: PART I. INVESTMENT STRATEGIES FOR THE GROWTH PATH, HOSTED BY 500 GLOBAL
Daniel Yergin - Vice Chairman, S&P Global
CAPITAL ALLOCATORS ROUNDTABLE
Shaikha Al Bahar - Deputy Group CEO, National Bank of Kuwait
SPORTSTECH-X: WHO’S SCORING BIG IN SPORTS-TECH? HOSTED BY SALTO VENTURES
Rajit Nanda - CEO, DataVolt
Jerry Inzerillo - Group CEO, Diriyah Gate Company
HOW IS RIYADH AIR SHAPING THE FUTURE OF TRAVEL DIGITALLY?
Masayoshi Son - CEO, SOFTBANK
Senator Matteo Renzi - Former Prime Minister of Italy
SAUDI CAPITAL MARKET: EXPLORING NEW FRONTIERS
Noah Horowitz - CEO, Art Basel
Abdulrahman Al-Fageeh - CEO, SABIC
EVO OF ALTS: PART I. TOKENIZATION OF REAL-WORLD ASSETS, HOSTED BY GALAXY INTERACTIVE
Bill Ford - CEO, General Atlantic
WHICH GIANTS WILL DOMINATE TOMORROW’S ENTERTAINMENT?
WHAT IS NEXT FOR JAPAN-MENA GEOECONOMIC RELATIONS?
Nick Candy - Property Developer, One Hyde Park
SECOND BOARD OF CHANGEMAKERS: BANKING & INVESTMENT
Jean Todt - Special Envoy for Road Safety, UN
HOW CAN WOMEN IN FINANCE DRIVE GLOBAL ECONOMIC GROWTH?
PART I: WHAT IS THE IMPACT OF RISING PRIVATE DEBT MARKETS?
Bill Ackman - Founder & CEO, Pershing Square Capital Management
President Donald J. Trump Delivers Special Address at FII PRIORITY Miami
FIRST BOARD OF CHANGEMAKERS: GEOECONOMICS
Sam Nazarian - CEO & Chairman, SBE Entertainment Group
Fettah Tamince - founder and chairman of Rixos Hotels
Eric Schmidt - Co-founder with his wife, Wendy, Schmidt Sciences; Former CEO & Chairman, Google, KBE
OPENING SHOW
Abdulrahman Al-Fageeh - CEO, SABIC
Majid Mufti - CEO, NEOM Investment Fund
Sir Martin Sorrell
CEO, S4 Capital & Founder, WPP plc
WHAT MACROTRENDS ARE BEYOND THE HORIZON?
LAUNCH OF SOVEREIGN AI GOVERNANCE ENGINE (SAGE)
Masayoshi Son - CEO, SOFTBANK
SECOND BOARD OF CHANGEMAKERS: BANKING & INVESTMENT
OPENING SPEECH
George Walker - Chairman & CEO, Neuberger Berman
Marcelo Claure
Founder & CEO, Claure Group
Sahit Muja - Chairman & CEO, Albanian Minerals
INTRODUCTORY SPEECH BY H.E. YASIR AL-RUMAYYAN
Mubarak Alwadaani - CCO, SCAI
HOW IS TECHNOLOGY DISRUPTING THE SKY?
BOARD OF CHANGEMAKERS: GEOECONOMICS
TRANSITION

FII PRIORIY ASIA 2025
Senator Matteo Renzi - Former Prime Minister of Italy
OPENING HORIZONS
INVESTING IN AI-DRIVEN PLATFORM TECHNOLOGY SHIFTS
WHAT HAPPENS WHEN DIGITAL SUPERINTELLIGENCE ARRIVES
ENABLING PURPOSE: HOW TO CREATE RESILIENT ECONOMIES FOR UNCERTAIN TIMES
Morad Fareed
Co-Founder, Delos
Mathieu Chabran - Co-Founder, Tikehau Capital

DAY2 - Thinking machines: Summit on artificial intelligence and robotics
Philippe Zuber - Chief Executive Officer for Kerzner International

New Global Order: View from Board of Changemakers FII6
PRIME MINISTERIAL ADDRESS
FOURTH BOARD OF CHANGEMAKERS: TECHNOLOGY & INNOVATION
BOARD OF CHANGEMAKERS: CAN LEADERS BUILD NEW FOUNDATIONS AMID GEOFRAGMENTATION?
FII8 Highlights
Rajit Nanda - CEO, DataVolt
BOARD OF CHANGEMAKERS:
PUBLIC-PRIVATE POWERBROKERS
THIRD BOARD OF CHANGEMAKERS: AI
Lourdes Rodriguez - CEO, David Rockefeller Foundation
Jerry Todd - Head of National Development Division, PIF
TRANSFORMING BUSINESS WITH AI: OPPORTUNITY OR OVERLOAD?
Shaikha Al Bahar - Deputy Group CEO, National Bank of Kuwait
Joerg Ambrosius - President, Investment Services, State Street
Best of FII 9th Edition
Ivan Espinosa - CEO, Nissan
Amanda Staveley - Owner, PCP Capital Partners
CAN CURRENT AI INFRASTRUCTURE KEEP UP WITH THE DEMANDS OF NEXT-GENERATION TECHNOLOGIES?
Massimo Calvelli - CEO, ATP
Bjorn Hovland - COO, CIQ
Edi Rama - Prime Minister of Albania
Gianni Infantino - President, FIFA
Final Wrap-Up
BOARD OF CHANGEMAKERS:
FINANCIAL MARKETS
Bill Ford - CEO, General Atlantic
ARE PRIVATE CREDIT AND ALT INVESTMENTS THE NEW KINGS OF WALL STREET?
Steve Cohen - Owner, New York Mets & CEO, Point72 Asset Management
President Donald J Trump Reaction - Eric Schmidt
Patrick Zhong
Founding Managing Partner, M31 Capital
Ambassador Stefano Pontecorvo - Chairman, Leonardo SpA
FUTURE OF ENERGY: WHAT WILL ACCELERATE THE ENERGY TRANSITION CURVE?
FII Priority Miami 2025 Highlights
The Debate - Matteo Renzi - Former Prime Minister of Italy & Mohamed Alabbar - Founder, Emaar Dubai
Neil Bush - Founder & Chairman, George H.W. Bush Foundation for US China Relations and Skytower Saudi Investments LLC
COMPETITIVELY ENERGIZING THE NEW ECONOMY: “THE SAUDI ENERGY BUFFET"
INDUSTRIAL SOVEREIGNTY: CAN EUROPE WIN THE TRADE GAME?
Travis Kalanick - CEO, CloudKitchens & Co-Founder, Uber
TITAN OF INDUSTRY
Gabrielle Rubenstein - Co-Founder, Manna Tree Partners
George Nazi - CEO, SCAI
Alaa Abdulaal - Chief of Digital Economy Foresight at the Digital Cooperation Organization
BOARD OF CHANGEMAKERS: CAN CAPITAL CONNECT A FRACTURED WORLD?
Round-Up - Welcome To FII9
Members Talk - Abdulmohsin Alomran - Founder & CEO, The Family Office
Global Trends, Part I: The Singularity is Here FII7

Board of Changemakers: H.E. Al-Rumayyan, Dalio, Dimon, Fraser, Motsepe and more FII7
Houssam Chahin - Chief of Climate Financing, UNHCR
The Debate - with Amanda Staveley & Jean Todt
HOW WILL FINANCIAL INSTITUTIONS BUILD THE NEXT ECONOMIC MEGAREGION?
Ibrahim Sagna - Executive Chairman, Silverbacks Holdings
Richard Attias
CEO, FII Institute
Mathieu Flamini - Entrepreneur & Former Professional Footballer
WHAT IS THE GEOPOLITICS OF TECHNOLOGY AFTER AI?
HOW DOES CULTURE SHAPE THE WORLD?
HOW FAR CAN INVESTMENT GO IN UNITING ALBANIA, EMERGING MARKETS, AND BEYOND?
H.E. Yasir Al-Rumayyan, Gov of PIF, Chairman of FII Institute, Shares Insights
TITAN OF INDUSTRY
Ferit Şahenk - Chairman, DOGUS Group
Baroness Ariane de Rothschild
CEO, Edmond de Rothschild Group
Fred Thiel - Chairman & CEO, MARA Holdings
The Debate - Elsa Hyland - Angel Investor & Azzi Agnelli - General Partner, Lifecycles
SAUDI & MENA INSIGHTS: WHAT DRIVES INVESTMENT PHILOSOPHIES IN EMERGING MARKETS?
WELCOME REMARKS
Maria Darhieh - Founder, Earth 05
Joerg Ambrosius - Executive Vice President, State Street
BOARD OF POLICYMAKERS: CAN LEADERS DELIVER OPTIMISM OVER CAUTION?
Nick Candy - Property Developer, One Hyde Park
Molly Duffy - Global Co-Head Financial Institutions Coverage, Standard Chartered
Dr Adah Almutairi - University of California
Dan Vahdat - Founder & CEO, Huma
OFFICIAL OPENING
Members Talk - Rohit Pareek - Chief Product Officer, Impresa.ai
SPECIAL CONVERSATION WITH H.E. YASIR AL-RUMAYYAN
CHAMPIONS' NEW ARENA: WHAT DOES IT MEAN TO INVEST WITH PURPOSE?
HOW WILL MOBILITY INNOVATION SHAPE THE EXPONENTIAL ECONOMY?
Impact for Humanity with Richard Attias and Gianni Infantino FII7
CAN HOSPITALITY AND TOURISM SHAPE A NEW ERA OF GLOBAL CONNECTIVITY?
Dr. Max Graham - Founder & CEO, Space for Giants
GLOBAL MARKETS IN 2025: REASONS FOR OPTIMISM & SAUDI ARABIA’S INVESTMENT EDGE
President Donald J Trump Reaction - Sir Martin Sorrell & Peter Diamandis
OPENING ADRESS
WHO IS LEADING THE WORLD IN AI?
Dr Subodh Kulkarni - President & CEO, Rigetti Computing
Plenary Session Highlights - The Global Race For AI Sovereignty
Peter Y Levin - Co-Founder & Managing Director, Griffin Gaming Partners
BOARD OF CHANGEMAKERS: A NEW ASIA
Gordan Pešić - CEO, DOK-ING Security and Defence
Motaz Al-Angari - Group Chief Investment Officer, stc group
The Debate - FII Innovators Pitch
Danny Townsend - CEO, SURJ Sports Investments
IS THIS THE CRYPTO RESURRECTION?
STARGATE AI: WHO WILL WIN THE $500 BILLION BET ON THE FUTURE OF INTELLIGENCE?
OPENING CONVERSATION WITH HIS EXCELLENCY YASIR AL-RUMAYYAN
Round-Up - Day 1 Highlights
WHICH GIANTS WILL DOMINATE TOMORROW’S ENTERTAINMENT?
FII Priority Europe - Welcome - 16th Round-Up
TITAN OF INVESTMENT
SPECIAL ADDRESS: H.E. Emmanuel Macron, President of the French Republic
OPENING SHOW
BUILDING THE ASIA OF TOMORROW
FUNDRAISING ROADSHOW I: OXFORD SCIENCE ENTERPRISES' PORTFOLIO
AI AT A CROSSROADS SERIES: PART I. BOOM, BUST, OR BREAKTHROUGH?
Sebastian Kurz - Former Chancellor of Austria
IS PRIVATE CREDIT IN A BUBBLE?

Board of Changemakers: Marcelo Claure, Jenny Johnson, Stephen Schwarzman and more
UNLOCKING MENA'S CAPITAL CONTINUUM: PART I. INVESTMENT STRATEGIES FOR THE GROWTH PATH, HOSTED BY 500 GLOBAL
Patrick Basham - Founding Director, Democracy Institute
The Debate - Linda Rama, Wife of the Prime Minister of Albania & Cecilia Attias, Former First Lady of France & member of FII Institute Board
IN CONVERSATION WITH HIS EXCELLENCY YASIR AL-RUMAYYAN
CAPITAL ALLOCATORS ROUNDTABLE
Dr. Kakoli Ghosh - Chief Technical Advisor, FAO
Marco Arcelli - CEO, ACWA Power
HOW WILL WOMEN DRIVE THE 5TH INDUSTRIAL REVOLUTION?
SHOULD ECONOMIC STRENGTH BE MEASURED BY CONSTRUCTING MORE OR CONNECTING BETTER?
Sarah Friar - CFO, OpenAI
Filip Ljubic - Founder and Chairman of Q Agency
Secretary Mike Pompeo - 70th Secretary of State of The United States & Executive Chairman, Impact Investments
INTELLIGENT CAPITAL, POWERED BY FII INSTITUTE IN PARTNERSHIP WITH THE HILL & VALLEY FORUM
ARE VALUE CHAINS STILL BUILT AROUND EFFICIENCY?
FII Priority Asia - Welcome - 30th November
WHAT IS THE FUTURE OF ESSENTIAL JOBS?
Daniel Yergin - Vice Chairman, S&P Global
WELCOME REMARKS
SPORTS SERIES: HOW IS SPORTS A PILLAR ASSET CLASS?
Bernard Mensah - President, Bank of America
Brian Strong - Chief Transformation Officer at SADAFCO
Dina DiLorenzo - President, Guggenheim Investments
Peje Emilsson - Founder, Kunskapsskolan Education
HOPE: HOW PEACE UNLOCKS PROSPERITY
WILL PUBLIC AND PRIVATE MARKETS CLASH OR CONVERGE?
ARE PARTNERSHIPS THE KEY TO SUSTAINABLE INDUSTRIAL DEVELOPMENT? POWERED BY ALAT
BOARD OF CHANGEMAKERS: THE ENERGY TRILEMMA
WILL PUBLIC OR PRIVATE MARKETS SHAPE THE FUTURE OF GLOBAL INVESTMENT?
Jean Todt - Special Envoy for Road Safety, UN
WHICH TECHNOLOGIES WILL DEFINE THE FUTURE OF FOOD?
Jenny Johnson - President & CEO, Franklin Templeton
Jan Alessie - Co-Founder & Managing Director, World Football Summit
Members Talk - Giovanna Della Posta - Founder & CEO, Discovery Investments
ALT ASSETS SERIES: PART I. CAN ALTERNATIVE ASSETS STILL BUFFER PORTFOLIOS DURING GEOECONOMIC STRESS?
SPECIAL CONVERSATION
CLASH OF THE TITANS: THE THREE GRAND CHALLENGES FACING HUMANITY
Sébastien Bazin - Group Chairman & CEO, ACCOR
Round-Up - Conference Highlights - 17th May
CAPITAL OF CHANGE:
CAN TOKYO REVITALIZE ITSELF AS THE NEXT GREAT FINANCIAL HUB OF THE WORLD?
IS A GLOBAL CONSENSUS ON CRYPTO EMERGING?
SPECIAL CONVERSATION
"BEYOND CAPITAL: THE SAUDI VALUE CREATION STORY" NEW FINDINGS FROM PIF, JADA & INSEAD
CAN THE OCEAN ECONOMY THRIVE IN THE NEXT INDUSTRIAL REVOLUTION?
Dr. Yoshihide Wada - Director of Biodiversity and Natural Resources, IIASA
Dr. Suliman Al-Khateeb - Assistant Deputy Minister of Agriculture, MEWA
IS A NEW ERA OF US-MIDDLE EAST ECONOMIC COOPERATION DAWNING?
Rishi Kapoor - Vice Chairman and CIO, Investcorp
OLD EUROPE, YOUNG VOICES: HOW IS THE NEXT GENERATION REDEFINING LEGACY, LEADERSHIP & THE FUTURE?
CAN STRATEGY MEET SPEED TO SOLVE THE WORLD’S ENERGY CHALLENGE?
CAN TECHNOLOGY DEEPEN HUMAN CONNECTION?
WILL THE GLOBAL ECONOMY ACHIEVE A SOFT LANDING?
SPECIAL ADDRESS BY A WORLD LEADER
IS PRIVATE REPLACING PUBLIC CREDIT IN EMERGING MARKETS?
SAUDI ARABIA'S AI REVOLUTION: A BLUEPRINT FOR GLOBAL INVESTORS
IS EUROPEAN INNOVATION REIGNITING?
IS HUMANITY HEADING IN THE RIGHT DIRECTION?
Makoto Takashima - Chairman of the Board, Sumitomo Mitsui Financial Group
Ibrahim Neyaz - CEO, National Technology Development Program (NTDP)
CAN REGIONAL MARKETS REINVENT GLOBAL FINANCE?
WHO WINS THE FUTURE OF AUTO?
IS THE GLOBAL SOUTH NOW THE ENGINE OF GROWTH?
HOW WILL FINANCE MANAGE RISK IN A FRACTURED WORLD?
WHAT WILL BE THE STATE OF THE GLOBAL ECONOMY POST-U.S. ELECTION?
Khaled AlQureshi - CEO, SWPC
eng.Ahmed Alkhamshi - Deputy Minister for Agriculture, MEWA
HOW CAN LEADERS NAVIGATE THE TECHNOLOGICAL REVOLUTION?
IS THE FUTURE OF TRANSPORTATION AUTONOMOUS?
Marko Pejković - CEO & Co-Founder, Verne
Jack Hidary - CEO, SandboxAQ
SHARK SNACKS
SAUDI'S MANZIL TAKES ON THE FUTURE OF WORKER HOUSING
Richard Attias - Chairman of the Executive Committee & Acting CEO, FII Institute
Camila Farani
CEO, G2 Capital
Tony Elumelu - Chairperson, United Bank of Africa
Christopher Nassetta - President & CEO, Hilton
Prince Fahd bin Mansour bin Nasser bin Abdulaziz
WHICH MARKETS WILL BUILD THE NEXT BIOTECH MEGACLUSTERS?
HOW CAN SWFs AND FAMILY OFFICES BUILD FORMALIZED CO-INVESTMENT PARTNERSHIPS POWERED BY MISA
Round-Up - Day 2 Highlight
WHICH ENERGY SOURCES ARE ASIA'S WINNING BET?
AI & DIGITAL TRANSFORMATION IN THE ASSET MANAGEMENT INDUSTRY
WORLD IN 2030
FII INNOVATORS PITCH 2025
WHO GAINS WHEN ROBOTS RISE?
Luciano Huck
TV Show Host & Entrepreneur
Norberto Giangrande Jr
Chairman of the Board, MINERVA FOODS
FUTURE DISRUPTORS, POWERED BY BETA LAB
Marco Mejia - CEO, King Salman Airport
Round-Up - Day 3 Highlights
Board of Changemakers - FIIPRIORITY in Hong Kong
WHAT IS THE MACRO OUTLOOK FOR REAL ESTATE AND HOUSING?
FUTURE OF RESOURCES: ARE CLEAN INDUSTRIES ACHIEVABLE?
INVESTING IN SUCCESS: WHAT LESSONS CAN WE LEARN FROM SPORTS & FINANCE?
FUNDRAISING ROADSHOW III: ARAMCO PORTFOLIO
Fabio Kestenbaum
Founding Partner, Positive Ventures
HOW WILL GOVTECH DRIVE ECONOMIC TRANSFORMATION THROUGH AI?
BEYOND GPT MODELS — WHAT IS THE DECADE AHEAD?
Noah Horowitz - CEO, Art Basel
Cécilia Attias
Former First Lady of France
HOW IS PIF RESHAPING GLOBAL SPORTS?
Achim Steiner - Administrator, UNDP
WHAT DO GPs REALLY STAND FOR
OFFICIAL REMARKS
OPENING CEREMONY AND WELCOME ADDRESS
Peter Diamandis - Founder & Chairman, XPRIZE Foundation
SAUDI CAPITAL MARKET: EXPLORING NEW FRONTIERS
Carme Artigas - Co-Chair, UN AI Advisory Board
Richard Haass - Senior Counselor, Centreview Partners
Plenary Session Highlights - Old Europe, Young Voices: How Is The Next Generation Redefining Legacy, Leadership & The Future?
HOW CAN TOKYO'S MANGA AND ANIME INDUSTRY FUEL A SURGE IN CREATIVE INVESTMENT?
CAN ENERGY GIANTS KEEP UP WITH AI?
Jorge Tuto Quiroga
Former President of Bolivia
Will Ahmed - CEO, Whoop
Xenia Wickett - Director, Wickett Advisory
PART I: WILL THE ENERGY REVOLUTION KEEP THE LIGHTS ON?
IS THE WORLD HEADING FROM FREE TO STRATEGIC TRADE?
IS BRAND A STRATEGIC ASSET IN FINANCE? POWERED BY PIF
Richard Rothenberg
CEO, Global AI
Adel Al-Jubeir
Saudi Arabian Minister of State for Foreign Affairs
HOW CAN EXPANDING RETAIL ACCESS TO PRIVATE MARKETS DEMOCRATIZE CAPITAL?
PIF ASSET MANAGEMENT FORUM
GLOBAL STARTUP SHOWCASE, FEATURING VENTURES CATALYZED BY HKSTP, FII INSTITUTE & WAVE
THE GLOBAL RACE FOR AI SOVEREIGNTY: WHAT ARE THE GEOPOLITICS OF THE AI VALUE CHAIN?
SYRIA'S NEW HORIZON: CAN REBUILDING BECOME A MODEL FOR GLOBAL COOPERATION?
HOW CAN WOMEN IN FINANCE DRIVE GLOBAL ECONOMIC GROWTH?
Jerry Inzerillo - Group CEO, Diriyah Gate Company
Dinner Talk - Idicula Mathew - Co-Founder & CEO, Hera Health Solution
Jay Koh
Co-Founder & MD, The Lightsmith Group
HOW IS RIYADH AIR SHAPING THE FUTURE OF TRAVEL DIGITALLY?
HOW CAN HEALTH STARTUPS ACCESS MORE DATA TO SCALE?
WHERE IS THE NEW SILK ROAD?
Petri Saarinen - Founder, Salto Ventures
Round-Up: Farewell From Tirana
WHAT IS THE BALANCE BETWEEN SOVEREIGNTY AND GLOBALIZATION?
HOW TO OPERATE THE WORLD'S BIGGEST PROJECTS
AI AND THE FUTURE OF TOURISM: UNLOCKING HUMAN POTENTIAL IN THE AGE OF INTELLIGENCE
Eduardo Paes
Mayor, Rio de Janeiro
IS GLOBAL HEALTH INFRASTRUCTURE READY FOR THE NEXT CRISIS?
WHICH EMERGING MARKETS ARE THE NEXT FRONTIER FOR ALTERNATIVE ASSET GROWTH?
Michael Dyke - CEO, New Murabba
WELCOME REMARKS
CAN CIRCULAR TECH AND NEW ENERGY ELEVATE A COUNTRY’S ECONOMIC STRATEGY?
[RISE OF THE AUTOMATA] WHAT HAPPENS WHEN ROBOTS PERFECT PHYSICAL INTELLIGENCE?
WHAT WILL WIN THE GLOBAL TRAVELER? PART 2: ULTRA-LIVING
Ray Dalio - Founder, CIO, Mentor & Member of the Board, Bridgewater Associates & Founder, Dalio Family Office
Innovator Debate - Leah Liu - Global Head of Capital Markets, VP, Insilico Medicine & Dr. Ahmed Ismail - Co-Founder & COO, Dunia Innovations GMBH
ECONOMIC DIPLOMACY AND METHODS OF RESILIENCE
: PATIENT CAPITAL IN AN IMPATIENT WORLD: LEVERS AND LESSONS IN VALUE CREATION, POWERED BY GENERAL ATLANTIC
Marc Ganis - Founder, Managing Director & President, Sportscorp Ltd
Jonathan Fascitelli - Founder & CEO, Seregh & Viktor Lechman - CEO, GMP Tech
Richard Attias - Chairman of The Executive Board, FII Institute
Michael Dell and Dina Powell Discuss Technology and Innovation
Gianni Infantino, President, FIFA, Speaks With Richard Attias, CEO, FII Institute
Vanda Witoto
Climate Activist & Leader of The Witoto People
IS THE GLOBAL SOUTH READY TO EMBRACE THE AI AND EMERGING TECH WAVE?
WHERE IS THE NEXT BIOTECH UNICORN?
Faraidon Saheb-Zadha - Managing Partner, Oros Capital
Patrick Pouyanné - Chairman & CEO, TotalEnergies
H.E. Manuel Marrero Cruz - Prime Minister, The Republic of Cuba
Dr. Ridha Wirakusumah - CEO, Indonesia Investment Authority (INA)
Titan of Industry with Cecilia Attias and Salwa Idrissi Akhannouch FII7
OPENING CONVERSATION
FII INSTITUTE ANNOUNCES THE AI.INCLUSIVE INITIATIVE
EVO OF ALTS: PART I. TOKENIZATION OF REAL-WORLD ASSETS, HOSTED BY GALAXY INTERACTIVE
Dino Varkey - Group CEO, GEMS Education
FII TALK: CAN LEADERS TURN MEGAPROJECTS INTO MEGASYSTEMS?
DECODING FDI TRENDS: WHERE IS GLOBAL INVESTMENT HEADING?
HOW ARE LEADERS BUILDING BUSINESSES FOR THE FUTURE?
Noah Alireza - CEO, Golf Saudi
IS GCC BECOMING THE NEXT GLOBAL FAMILY OFFICE HUB POWERED BY MISA
PART I: WHAT IS THE IMPACT OF RISING PRIVATE DEBT MARKETS?
WHICH VC HOTSPOTS WILL DRIVE THE NEXT PHASE OF DISRUPTION?
SPORTSTECH-X: WHO’S SCORING BIG IN SPORTS-TECH? HOSTED BY SALTO VENTURES
CAN LEADERS DECODE THE REAL ESTATE ALGORITHM?
Ahmed Al-Subaey - Board Member, Golf Saudi & CEO, Bahri
THE INVESTOR'S GUIDE TO GLOBAL CRISES
H.E. Yoriko Koike - Governor of Tokyo
WHAT IS THE NEW NORMAL IN 2025 FROM BONDS TO RISK ASSETS?
WHAT NEW TECHNOLOGIES CAN SECURE ENERGY FOR THE NEXT CENTURY?
CAN TRADITIONAL BANKS COMPETE WITH AI AND FINTECH DISRUPTORS?
HOW CAN BUSINESSES ADAPT TO INDUSTRY 5.0?
RISK OR REVOLUTION, A CONVERSATION WITH MOONSHOT CEOS, MARC LORE & SAM NAZARIAN
WILL TECH COMPANIES BE MORE POWERFUL THAN GOVERNMENTS?
Ted Leonsis - CEO, Monumental Sports & Entertainment
Sir Noel Quinn - Board of Trustees, FII Institute
WHAT WILL BE THE PRIME INFRASTRUCTURE ASSETS OF 2030?
HOW SAUDI FAMILY OFFICES SPOT UNICORNS, POWERED BY MISA
Eric Cantor - Vice Chairman & Managing Director, Moelis & Company & Former US House Majority Leader
SPECIAL REMARKS FROM THE MINISTRY OF FINANCE
FII INNOVATORS PITCH RIO 2024
WHAT WILL UNLOCK THE NEXT WAVE OF GROWTH IN CHINA?
Orlando Bravo - Founder & Managing Partner, Thoma Bravo
Mona Dajani - Global Co-Chair of the Energy, Infrastructure and Hydrogen, Baker Botts
CONNECTING THE CURRENTS—THE NEXT POWER PLAY IN PHYSICAL-TO-DIGITAL INFRASTRUCTURE
[CAPITAL OF AI] WHAT DOES IT TAKE TO CREATE INTELLIGENCE?
FUTURE FLASH: TRANSFORM HOW WE ENERGIZE THE WORLD
Ramez Shehadi - Senior Managing Director, Accenture
Professor Yanis Ben Amor - Columbia University
SPECIAL REMARKS BY THE MINISTRY OF ECONOMY, TRADE, AND INDUSTRY
Haruki Satomi - President & CEO, Sega Sammy Holdings
Sandro Salsano
President, Salsano Group
WHERE ARE THE NEW GLOBAL SUPPLY CHAINS?
FII INNOVATORS PITCH 2024
FII ANNOUNCES THE #HEALTHYHUMANITY INITIATIVE
FII8 CLOSING REMARKS
Nicholas Ho - Commissioner For Belt & Road, Hong Kong Government
Dr Abdulhamid Alkhalifa - President, The OPEC Fund for International Development
Sanford Climan - CEO, Entertainment Media Ventures
Mate Rimac - CEO, Rimac Group
Amanda Staveley & Mehrdad Ghodoussi - Co-Directors, PCP Capital Partners UK
HAS PRIVATE EQUITY MOVED BEYOND THE BUYOUT?
CAN INDUSTRIAL INTELLIGENCE CREATE ALPHA AMID GEOPOLITICAL UNCERTAINTY & SUPPLY CHAIN CHALLENGES?
Dr. Neeraja Nagarajan, MD, MPH - McKinsey Health Institute
Elena Doms - Founder, Earth Plus
FROM PREVENTION TO PRECISION: IS BIOTECH THE ANSWER?
HOW PATRIOTIC CAPITALISM IS CHALLENGING THE STATUS QUO
KEY DEBATE: WILL CREDIT OR EQUITY DOMINATE THE MODERN PORTFOLIO?
FUNDRAISING ROADSHOW II: ARAMCO PORTFOLIO
Richard Attias, FII Institute CEO, Delivers Opening Remarks
SPECIAL ADDRESS EGYPT
WHERE ARE THE NEW CENTERS OF DIGITAL GROWTH?
RESHAPING THE ASSET MANAGEMENT INDUSTRY IN SAUDI ARABIA, WHAT HAS BEEN ACHIEVED SO FAR?
UNLOCKING MENA'S CAPITAL CONTINUUM: PART II. LOCAL MARKET DYNAMICS & GLOBAL VALUATION ALIGNMENT, POWERED BY INSEAD & JADA FUND OF FUNDS
TITAN OF INDUSTRY
Barron Joseph Orr - UNCCD, Chief Scientist
THE NEXT FRONTIER: CAN THE SPACE ECONOMY REDEFINE OUR FUTURE?
RETHINKING POWER: WHO LEADS, HOW, AND WHY IN EUROPE TODAY?
CAN EMERGING DESTINATIONS REDRAW THE TOURISM MAP?
Samir Mane - President, Balfin Group
IS THE LEGACY AVIATION ECOSYSTEM RIPE FOR AI DISRUPTION? POWERED BY RIYADH AIR
[CAPITAL OF AI] WILL COMPUTE BECOME A GLOBAL RESOURCE?
NEW ENTITY LAUNCH
IS A NATION'S GREATEST ASSET NOW ITS MOST VOLATILE?
HOW TO BUILD A WORLD-CLASS EXPO
WILL AI-OPTIMIZED HOSPITALS OUTPERFORM TRADITIONAL ONES?
Martin Gilbert - Chairman, Revolut & Founder & Former CEO, Aberdeen Asset Management
DEB(AI)TE: ROUND I. DO MODELS TRULY REASON OR MIMIC REASONING?
HOW CAN ECONOMIC DIPLOMACY ADVANCE GLOBAL COOPERATION?
WILL AI DEFINE THE FUTURE OF WORK?
INVESTMENT DAY WELCOME
UNLOCKING AND NAVIGATING MENA PRIVATE MARKETS
CAN THE ENERGY TRANSITION SURVIVE ITS OWN COMPLEXITY?
Danny Townsend - CEO, SURJ Sports Investments
Rakan Tarabzoni - COO, FII Institute
Members Talk - Viktor Lechman - CEO, GMP Tech
BOARD OF CHANGEMAKERS: PRIVATE CAPITAL
VIBE CODERS! VIBE CODERS! VIBE CODERS!
The Debate - Tony Douglas – CEO, Riyadh Air & Ed Bastian – CEO, Delta
Eng. Talal H. Almarri - CEO, Expo 2030 Riyadh Company
Fadi Saadeh - Acting CEO, VCM
Nelson Barbosa
Director of Project Planning & Structuring, BNDES, former Minister of Finance of Brazil
IS SLOWER GROWTH ON THE HORIZON FOR PRIVATE EQUITY FIRMS?
HOW WILL ESPORTS CREATE A NEW GLOBAL OLYMPIC ARENA?
WHAT TECHNOLOGIES BENEFIT THE MOST FOR AI ENABLEMENT?
Dan Schulman - Vice Chairman & Managing Partner, Valor Capital Group
Valerie Hickey - Global Director for Environment, The World Bank
Jim Keller - CEO, Tenstorrent
PART II:WILL THE ENERGY REVOLUTION KEEP THE LIGHTS ON?
Stefano Buono - Chairman & Founder, Newcleo
Francois Barrault - Chairman, Digiworld Institute
HOW CAN CITIES ATTRACT INVESTMENT WHILE PRIORITIZING CITIZENS IN THE TECH-CENTRIC ERA?
[PIF GLOBAL ASSET MANAGEMENT FORUM]
FIRESIDE WITH H.E. EL-KUWAIZ
Jonathan Berman – CEO, Shell Foundation
HOW CAN CITIES LEAD ECONOMIC REGENERATION?
WHAT IS THE FUTURE OF TRUST AND SECURITY IN THE AGE OF AI?
BIG DATA, BIG POWER: WHO HOLDS THE GLOBAL REINS?
[AI INVESTMENT SUMMIT] CONVERSATION WITH THE MOONSHOTS PODCAST TEAM ON AI INVESTMENTS
Bonnie Y. Chan – CEO, Hong Kong Exchanges & Clearing Limited (HKEX)
Cécilia Attias - Founder & President, Cecilia Attias Foundation for Women & Former First Lady Of France
THE LANDSCAPE OF AFRICAN ENTREPRENEURSHIP: HOW CAN VISION TRANSFORM TO VENTURE?
WHAT ARE THE INVESTMENT RISKS & OPPORTUNITIES OF A RISING AFRICA?
WILL WOMEN ENTREPRENEURS SOLVE THE WORLD’S MOST DIFFICULT SOCIETAL PROBLEMS?
BRIDGING BORDERS: WHAT ARE LEADERS’ LESSONS TO THE NEXT GENERATION?
WHO WILL BUILD A RESILIENT AND SUSTAINABLE ENERGY INFRASTRUCTURE?
TITAN OF INDUSTRY
Deniz Tekerek - Co-Founder & CCO, Archireef
Jay New - CEO, King Abdullah Port
Michal Katz - Head of Investment & Corporate Banking, Mizuho Americas
SOVEREIGN WEALTH AND INSTITUTIONAL CAPITAL IN THE NEW POWER ECONOMY
CAN THE ENERGY INDUSTRY DE-RISK GREEN HYDROGEN? POWERED BY NEOM
THE FUTURE IS ENGINEERED: AI, BIOTECH, AND THE RISE OF STRATEGIC INNOVATION HUBS
Jackson Eisenpresser – CEO, ABG Advisory
The Debate - Thomas J. Lee - Co-Founder & Head of Research, Fundstrat & Chairman, Bitmine & Christopher Buskirk - Founder & CIO, 1789 Capitals
WELCOME REMARKS
Members Talk - Devi Sahny - Founder & CEO, Ascend Now
H.E. Yasir Al-Rumayyan with Ruth Shapiro on Humanity's Priorities FII PRIORITY Hong Kong
Global Trends, Part II: The Board of the Future FII7
PART II: WHAT IS THE IMPACT OF RISING PRIVATE DEBT MARKETS?
WILL INTELLECTUAL PROPERTY SURVIVE?
WHAT IS THE AIR MOBILITY REVOLUTION?
Alisher Shukurov - Deputy Minister of Agriculture, Republic of Uzbekistan
Carlos Duarte - Chief Scientist, WAVE
Ricardo Salinas - Founder & Chairman, Grupo Salinas
ARE NATIONAL FUNDS OUTPACING MULTILATERALS?
IS INNOVATION ENOUGH TO SECURE ENERGY FOR HIGH-STAKES SECTORS?
ZERO TO FOUR: HOW VC FIRMS EVOLVE FROM FUND TO FIRM, FIRM TO FRANCHISE" NEW FINDINGS FROM KAUFFMAN FELLOWS
IS THE BRAIN THE FINAL FRONTIER?
Barry Sternlicht - Chairman & CEO, Starwood Capital Group
Bob Willen - Global Managing Partner & Chairman of the Board, Kearney
WHAT CAN OVERCOME THE BARRIERS TO NEXT-GEN TRANSPORTATION?
HOW WILL AI AND BIG DATA ACCELERATE SUSTAINABILITY IN THE ENERGY SECTOR?
THE ART OF THE EXIT: IPOs, ACQUISITIONS & BEYOND, A MASTERCLASS ON STRATEGY, POWERED BY VCPEA
GLOBAL STARTUP SHOWCASE, FEATURING ARAMCO VENTURES & NTDP PORTFOLIO COMPANIES
Dr. Osama Faqeeha - Deputy Minister for Environment, Ministry of Environment, Water and Agriculture, and Advisor to the UNCCD COP16 Presidency
Daniel Tsegai - Programme Officer, UNCCD
Michael Tian - Chairman of Horizon Water
WILL MARKETS SURVIVE THE $100 TRILLION DEBT CRISIS?
IS AI-DRIVEN WELLNESS THE FUTURE OF CARE?
Dinner Talk - Sajid Javid - Partner, Centricus Partners LLP & Former UK Chancellor of The Exchequer
WELCOME REMARKS BY RICHARD ATTIAS
PRIME MINISTERIAL ADDRESS: H.E. Edi Rama, Prime Minister, Republic of Albania
MUST EVERY C-SUITE LEADER NOW THINK LIKE A CISO?
BUILDING FOR MILLIONS: WHAT'S THE FUTURE OF HOSPITALITY IN MECCA AND MEDINA?
WHAT IS THE KEY TO REAL MACROECONOMIC STABILITY?
HOW DOES DEEP TECH SURVIVE HYPE CYCLES?
Scott O'Neil - CEO, LIV Golf
Innovator Debate - Dr. Meshari Alwashmi – CEO, AmplifAI
Round Up: Farewell from Tokyo
Tomohiro Fujita - CEO, CHITOSE Group
Transforming Healthcare Through Technology with Dr. Mehmet Oz and Sam Nazarian
MESSAGE TO G20: HOW CAN GLOBAL CAPITAL TURBOCHARGE THE GLOBAL SOUTH?
SPECIAL ADDRESS PAKISTAN
HOW ARE DEMOGRAPHIC SHIFTS IMPACTING INVESTMENT STRATEGIES?
HOW ARE VENTURE FIRMS PREPARING FOR A NEW ERA OF RESILIENCE?
TAPPING INTO ARAMCO'S VALUE CHAIN: A GUIDE FOR STARTUPS & CEOs, PRESENTED BY ARAMCO VENTURES & WA’ED VENTURES
WHO WILL BUILD THE NEXT PREMIER GLOBAL DESTINATION HUB?
Robert Simonds - Founder & CEO, STX Entertainment
Cecilia Attias - Former First Lady of France
Aly Abousabaa - ICARDA Director General and CGIAR Regional Director for Central & Western Asia & North Africa
Patrick Zhong - Founding Managing Partner, M31 Capital
Amir & Zaib Husain - Co-Founders, Argon Mechatronics
Alexander Sukharevsky - Senior Partner & Managing Partner, QuantumBlack, AI by McKinsey
Mohsen Moazami - Office of the CEO, President International, Groq
SHOULD TRANSFORMATIVE INVESTMENTS MEASURE IMPACT OVER PROFIT? POWERED BY NEW MURABBA
SAUDI SECTOR SPOTLIGHT ON PETROCHEMICALS & ENERGY, POWERED BY PIF GLOBAL ASSET MANAGEMENT FORUM
IS FDI PULLING AWAY FROM THE WEST?
[CAPITAL OF AI] FUTURE FLASH: HOW AI GLASSES WILL CHANGE THE WORLD
WILL EUROPE LEAD ITS OWN DEFENSE RENAISSANCE?
[PIF GLOBAL ASSET MANAGEMENT FORUM]
BUILDING BRIDGES: HOW SAUDI AND GLOBAL ASSET MANAGERS CAN SEIZE NEW OPPORTUNITIES
Sébastien Bazin – Chairman & CEO, Accor
Dr. Noubar Afeyan - Founder & CEO, Flagship Pioneering Co-Founder, Moderna
SECURING THE NEW INDUSTRIAL SUPPLY CHAIN
Andy Rubin - Founder & CEO, Genki Robotics, Android & Danger
MAXIMIZING IMPACT AND ACCELERATING SOLUTIONS: HOW CAN WOMEN IN FINANCIAL LEADERSHIP CHANGE THE GAME?
WHO CAN TAKE GREEN HYDROGEN TO NEW HEIGHTS?
INVITE ONLY: FRANKLIN TEMPLETON BREAKFAST & PANEL DISCUSSION
WORLD LEADER SPECIAL ADDRESS
WHO IS LEADING INNOVATION IN SAUDI ARABIA'S NEW BIOTECH ERA?
Dinner Talk - Avram Glazer - Owner, Tampa Bay Bucaneers & Manchester United
Dinner Talk - Amanda Staveley - Owner, PCP Capital Partners
John Keppler - Executive Chairman, iyris inc.
Professor Tony Chan - Former President of King Abdullah University
HOW CAN A GLOBAL LOGISTICS HUB BE BUILT FROM SCRATCH? POWERED BY KING SALMAN INTERNATIONAL AIRPORT (KSIA)
WHAT DOES IT TAKE TO BUILD A NATION’S ESSENTIAL INDUSTRIES?
VENTURE BUILDER IN FOCUS: OXFORD SCIENCE ENTERPRISES
The Debate - John Martin – CEO, Professional Fighters League (PFL) & Biaggio Ali Walsh – Fighter, Professional Fighters League (PFL)
Chris Arsenault - Co-Founder & Partner, Inovia
CAN CULTURE & ENTERTAINMENT FUEL ECONOMIC EXPANSION?
Opening Remarks with Richard Attias, CEO, FII Institute
POWERING AFRICA: WHAT IS THE FUTURE OF ENERGY INVESTMENTS?
HOW CAN BUSINESSES REACH FINANCIAL TARGETS WHILE CREATING POSITIVE IMPACT?
WHAT IS THE INDUSTRY OUTLOOK FOR SUBSAHARAN AFRICA?
HOW ARE EARLY AND LATE-STAGE FUNDS CONVERGING?
HOW ARE INVESTMENT FUNDS EVOLVING THEIR FUNDRAISING STRATEGIES?
DRIVING GLOBAL INNOVATION & INVESTMENT OPPORTUNITIES TO SAUDI ARABIA HOSTED BY NIF & STARTUP20
Ali Russell - Managing Director, Extreme H
IS FINANCIAL DEGLOBALIZATION REVERSIBLE?
WHAT WILL DETERMINE THE FUTURE OF ENERGY DEMAND?
PAVING THE WAY TO GLOBAL MINERAL SECURITY
EXPO 2030 RIYADH x FII INSTITUTE
[AI INVESTMENT SUMMIT] WHAT IS THE FUTURE OF WORK IN THE AGE OF AI?
HOW CAN LEADERS THRIVE IN A WORLD OF RELENTLESS PRESSURE?
WHY ARE THE SMARTEST POWER PLAYERS ALL IN ON WOMEN’S SPORTS? POWERED BY PIF
WILL HISTORY REWARD THOSE WHO 'MOOVE' FIRST?
[PIF GLOBAL ASSET MANAGEMENT FORUM]
OPENING REMARKS
IS THE GCC BECOMING A NEW STRATEGIC ANCHOR FOR THE GLOBAL VC ECOSYSTEM?
HOW CAN VCs MASTER DILIGENCING DEEP TECH IP IN CLIMATE AMID R&D RISKS?
Deemah Alyahya - Secretary-General, Digital Cooperation Organization (DCO)
Kei Nakamura - Senior Managing Executive Officer, Co-Head of Global Banking Unit, SMBC
Members Talk - Daniela Braga - Founder & CEO, Defined.ai
HOW CAN THE FINTECH REVOLUTION BRIDGE THE FINANCIAL INCLUSION GAP?
WELCOME REMARKS
THE GREEN TRANSITION: HOW CAN WOMEN POWER SUSTAINABLE SUPPLY CHAINS?
IS GREEN SHORING THE FUTURE OF A TRULY GLOBAL BUSINESS?
HOW CAN AI DEMOCRATIZE HEALTH FOR THE NEXT BILLION?
WHAT PUBLIC POLICIES WILL ENSURE ETHICAL AI?
WILL 2025 BE THE YEAR OF GREEN SUPPLY CHAINS?
PART I: CAN SMARTER SUSTAINABILITY UNLOCK NET-ZERO?
Prem Akkaraju - CEO, Stability AI
WHAT ARE THE COMPETING VISIONS FOR THE WORLD'S FINANCIAL CENTERS?
IS RESILIENCE THE NEW MEASURE OF CORPORATE STRENGTH?
IS MORTALITY DEAD?
WHAT WILL WIN THE GLOBAL TRAVELER? PART 1: TOURISM
INSIDE SAUDI ARABIA'S DEEP TECH ECOSYSTEM, POWERED BY NTDP
EQUITY OVER ENDORSEMENTS: HOW TO BACK INFLUENCE-DRIVEN VENTURES
The Debate - Marco Arcelli - CEO, ACWA Power & Marco Mejia - CEO, King Salman International Airport
GAMING, TALENT, AND TOMORROW’S SOCIETY
Climate Tech: Can Jet-Zero Be Achieved?
PUBLIC-PRIVATE PARTNERSHIPS: HOW CAN COLLABORATION DRIVE DEVELOPMENT IN THE NEW AFRICA AND MIDDLE EAST?
WHAT IS THE FUTURE OF IMPACT INVESTING?
WHAT WILL GLOBALIZE INNOVATIVE MOBILITY?
FII8 ANNOUNCEMENT / GLOBAL FUTUR OF WORK COMPASS
HOW WILL AEROSPACE SHAPE THE FUTURE OF THE GLOBAL ECONOMY?
Faraidon Saheb-Zadha - Managing Partner, Oros Capital Partners
WHAT MAKES A SUCCESSFUL AI COMPANY?
IS MMA THE MIDDLE EAST'S NEXT BIG SPORTS SECTOR?
[PIF GLOBAL ASSET MANAGEMENT FORUM]
THE EVOLVING SAUDI MARKET - A NEW FRONTIER FOR ASSET MANAGERS
[PIF GLOBAL ASSET MANAGEMENT FORUM]
FROM CONVICTION TO ALLOCATION: MARKET DEPTH, LIQUIDITY, & TRADABILITY
FUNDS IN FOCUS: ARAMCO & WA'ED VENTURES
SHARPER TECH – SAFER WORLD?
CAPITAL CATALYSTS: ASIA’S POWER EXCHANGES
WHAT TRENDS ARE EMPOWERING AFRICA’S YOUNG ENTREPRENEURS?
WHAT IS NEXT FOR JAPAN-MENA GEOECONOMIC RELATIONS?
WHAT IS EUROPE'S ECONOMIC OUTLOOK?
WHAT LOCAL STRATEGIES WILL ENSURE A SUCCESSFUL ENERGY TRANSITION?
HOW WILL PLASMA THERAPY INNOVATIONS IMPROVE HEALTH OUTCOMES?
HOW WILL EMBEDDED FINANCE TRANSFORM TRADITIONAL FINANCIAL SERVICES?
25 OUTLOOK SERIES: PART I. WHERE IS INNOVATION HEADING? POWERED BY BICYCLE CAPITAL
Wesam Alghamdi - CEO, NEOM Green Hydrogen Company
Michael Haddad - Goodwill Ambassador, UNDP
Members Talk - Akshay Chaturvedi - Founder, Leverage Edu
COORDINATING THE TRILLION DOLLAR BUILD OUT—THE NEXT POWER PLAY IN PHYSICAL-TO-DIGITAL INFRASTRUCTURE
AI INFRASTRUCTURE: THE NEW BACKBONE OF GLOBAL LEADERSHIP, POWERED BY FII INSTITUTE IN PARTNERSHIP WITH THE HILL & VALLEY FORUM
HOW CAN NATIONS THRIVE IN TIMES OF WAR?
HONG KONG'S WESTWELL REINVENTS LOGISTICS WITH AUTONOMY-DRIVEN SYSTEMS
STV & GOOGLE BRIDGE THE REGIONAL AI APP GAP
THE STORY BEHIND THE STORIES
Michael Dyke – CEO, New Murabba
Secretary Steven Mnuchin - 77th Secretary of Treasury of The United States
The Debate - Peter H. Diamandis - Board Member, FII Institute & Jack Hidary - CEO, SandboxAQ
Dr. Angela Wilkinson - Secretary General, World Energy Forum
Members Talk - Mike Goguen - Founder & CEO, Two Bear Capital
How is Saudi Arabia Resetting the Global Investment Equilibrium?
CAN WE POP THE FILTER BUBBLE IN AFRICAN ENTERTAINMENT?
HOW CAN AFRICA LEAD THE FIGHT AGAINST FOOD INSECURITY?
HOW WILL SUPPLY CHAINS ORGANIZE IN THE FUTURE?
HOW CAN THE ENERGY TRANSITION BE FINANCED WHILE ENSURING GLOBAL ENERGY SECURITY?
ARE TODAY’S BUSINESS MODELS READY FOR TOMORROW’S CONSUMER?
HOW IS FINTECH EVOLVING ACROSS MARKETS?
ANNOUNCEMENT & SIGNING CEREMONY
WHAT ARE THE NEW MODELS ACCELERATING EDUCATIONAL OUTCOMES?
HOW WILL INDUSTRY 5.0 OPTIMIZE THE HUMAN-MACHINE SYMBIOSIS?
25 OUTLOOK SERIES: PART II. WHAT IS HAPPENING OUTSIDE SILICON VALLEY? POWERED BY BICYCLE CAPITAL
Anthony Vinciquerra - Chairman & CEO, Sony Pictures Entertainment
IS HUMAN POTENTIAL THE WORLD'S MOST UNDERVALUED ASSET?
HAS THE MENA MOMENT ARRIVED FOR INVESTORS?
AI & THE WHITE HOUSE, POWERED BY FII INSTITUTE IN PARTNERSHIP WITH THE HILL & VALLEY FORUM
[AI INVESTMENT SUMMIT] HOW DO YOU SPOT AN AI UNICORN AT SEED STAGE?
FUTURE FLASH: CAN ORBITAL DATA CENTERS OUTPACE EARTH'S LIMITATIONS?
FUTURE FLASH: THE QUANTUM-AI REVOLUTION
FUNDS IN FOCUS: WYLD VC & BEENEXT
SELL OR SCALE? NAVIGATING THE AI-DRIVEN M&A SURGE
The Hon. E. David Burt, JP - MP Premier of Bermuda Government of Bermuda
WHAT DEFINES THE NEXT GREAT DESTINATION?
Round Up - Summit Highlights - 1st December
Ichiro Takahara - Chairman & CEO, Japan Organization for Metals & Energy Security
Riken Yamamoto - Architect, Riken Yamamoto & Field Shop
Members Talk - Manoj Madnani - Managing Director for EMEA, MARA
Who Will Navigate the Era of Megashocks? FIIPRIORITY Hong Kong
FII ESG London - S010 | How Asset Managers / Sovereign Wealth Funds Are Financing the Future of ESG
WHEN WILL THE IPO OUTLOOK TURN POSITIVE?
HOW WILL MACRODYNAMICS IMPACT THE FUTURE OF NATURAL RESOURCES?
SPORTS SERIES: IS ENHANCED THE FUTURE OF SPORTS?
PART II: CAN SMARTER SUSTAINABILITY UNLOCK NET-ZERO?
Graham Strong - Chief Impact Officer, World Vision
FUTURE FLASH: CAN AGING BE OUR GREATEST OPPORTUNITY?
CAN DE-RISKING THE ENTREPRENEURSHIP ECOSYSTEM DRIVE SMARTER INVESTMENT? POWERED BY MISA
HOW IS PATIENT CAPITAL SETTLING AFTER THE TRADE WAR?
[AI INVESTMENT SUMMIT] HOW WILL WE FUND THE GLOBAL AI REVOLUTION?
WHAT IS THE PRIVATE SECTOR SOLUTION TO DECARBONIZATION?
[AI INVESTMENT SUMMIT] WHAT WILL BE THE FIRST TRILLION-DOLLAR AI USE CASE?
FUTURE FLASH: WHAT IS THE TRAJECTORY OF URBAN LIVING?
WHAT INNOVATIVE FINANCING MECHANISMS ARE SCALING CLIMATE-SMART TECHNOLOGIES?
[PIF GLOBAL ASSET MANAGEMENT FORUM]
HARNESSING DATA: THE EVOLVING ROLE OF QUANTITATIVE INVESTING IN MODERN PORTFOLIOS
CLOSING REMARKS
Jeff Hoffman – Chairman, Global Entrepreneurship Network
Manfredi Lefebvre D'ovidio – Chairman, WTTC
Daniel Yergin - Vice-Chairman, S&P Global
Matteo Renzi - Former Prime Minister of Italy
Prof. Naoko Ishii - Director, Center for Global Commons, University of Tokyo
Climate After COP28 FIIPRIORITY Hong Kong
DAY3 - Future flash: Andrew McAfee
MEA SMART CITIES: WHAT ARE THE BUILDING BLOCKS OF URBAN ECOSYSTEMS OF THE FUTURE?
WHO WILL REINVENT THE SKYSCRAPER?
WILL AI-GENERATED ENTERTAINMENT REPLACE HUMAN CREATIVITY?
ARE FEMALE INNOVATORS BEING SHORTCHANGED?
CEO ROUNDTABLE WITH 10 HYPERSCALE FOUNDERS, HOSTED BY AVRA FUND
Andrew Liveris - Former CEO & Chairman, Dow Chemical Group
Professor Johan Rockström - Director of the Potsdam Institute for Climate Impact Research
Mariana Atencio - Journalist, TV Host & Author
President Macron Address Reaction - Justin Doherty - FII Institute & Adrian Hoxha - Honorary Consul, Latvia
Plenary Session Highlights - Board of Changemakers: Can Captial Connect A Fractured World?
Plenary Session Highlights - Big Data, Big Power: Who Holds The Global Reins?
Plenary Session Highlights - From Prevention To Precision: Is Biotech The Answer?
THE DOLLAR VERSUS THE CODE
CRITICAL MINERALS, CRITICAL ALLIES, POWERED BY FII INSTITUTE IN PARTNERSHIP WITH THE HILL & VALLEY FORUM
WILL WE POWER THE FUTURE WITH THE ATOM, THE SUN, OR THE STARS?
FUTURE FLASH: HOW BIG THINGS GET DONE
CAN THE COMMERCIAL SPACE RACE SURVIVE ASTROPOLITICS?
FROM FIRST CHECK TO FULL STACK, INSIDE THE DEAL THAT TURNED A BIOTECH BET INTO A $1B PLATFORM
IS ALPHA AT THE FUSION OF SPORTS AND ENTERTAINMENT? POWERED BY PIF
ALL-STAR WELLNESS—TECH SLAMS THE $92.5B SPORTS MARKET
FUTURE FLASH: CAN A PRIVATE DIGITAL CURRENCY DELIVER PUBLIC FINANCIAL STABILITY?
WHO WILL DISRUPT, AND WHO WILL BE DISRUPTED?
2026 GLOBAL VENTURE OUTLOOK
TURNING IDEAS INTO MARKET-LEADING GROWTH, A MASTERCLASS WITH JEFF HOFFMAN
Tobjorn Caesar - Senior Partner & Chairman, ACTIS
HOW TO CAPTURE ALPHA IN PRODUCT-CENTRIC PORTFOLIOS
[PIF GLOBAL ASSET MANAGEMENT FORUM]
PRIVATE CAPITAL MARKET TRENDS IN THE MENA REGION: RISKS, REWARDS, AND ROADMAPS
IS THE SFO-RUH PACT THE ULTIMATE PLAY FOR VC DOMINATION
ARE GP STAKES THE WAGYU OF PRIVATE CAPITAL?
[RISE OF THE AUTOMATA] WHICH HUMANOID ROBOT WILL YOU HAVE AT HOME?
Ebru Özdemir - Chairwoman, Limak Holding
Patrick Basham – Director, Democracy Institute
H.E. Dr. Majid Ibrahim Al-Fayyadh - CEO, King Faisal Specialist Hospital & Research Centre
Yoshinori Kenehana - Chairman of the Board, Kawasaki Heavy Industries Ltd
Christian Garrett - Partner 137 Ventures, Co-Founder Hill & Valley Forum
Erik Ringvold - Chief Business Development Officer, VCM
WHAT ARE THE INNOVATIONS DEMOCRATIZING FINANCE?
WHERE WILL THE SPACE INDUSTRY GO NEXT?
HOW ARE CARBON MARKETS EVOLVING?
INSIDER EXCLUSIVE: 2024 KAUFFMAN FUND RETURNER INDEX, POWERED BY KAUFFMAN FELLOWS
UNLOCKING MENA'S CAPITAL CONTINUUM: PART IV. FOUNDERS' SECRETS & SUCCESSES TO THE SAUDI MARKET, POWERED BY NTDP
ANNOUNCEMENTS & SIGNING CEREMONY
Dr. Khaled Khalifa - Senior Advisor & Representative to High Commissioner, UNHCR
Ms Jing Sun - Head of Desertification Department, Society of Entrepreneurs & Ecology Foundation
DO STATES OWN THE OCEAN?
Plenary Session Highlights - Rethinking Power: Who Leads, How And Why In Europe Today
Plenary Session Highlights - Can Emerging Destinations Redraw The Tourism Map?
THE PARADOX OF THE MEGADEAL
CAN AI’S ENERGY APPETITE BE SUSTAINABLY FUELED? POWERED BY FII INSTITUTE IN PARTNERSHIP WITH THE HILL & VALLEY FORUM
CAN CELL-BASED INNOVATION KEEP HUMANITY IN PEAK CONDITION?
HOW TO OPTIMIZE ORGANIZATIONS FOR MASSIVE DEVELOPMENTS
WHAT HYPERSCALE CEOs NEED TO PERSEVERE
DEB(AI)TE: ROUND II. WHICH PATH WILL DOMINATE THE FUTURE OF AGENTIC AI?
DEB(AI)TE: ROUND III. SHOULD POWERFUL OPEN-SOURCE AI MODELS, WITHOUT SAFEGUARDS, BE BANNED TO PREVENT CATASTROPHIC MISUSE?
IS EVERY COMPANY BEING REWRITTEN BY AI?
CAN INDIA’S GROWTH REFORMS FUEL A GLOBAL STARTUP WAVE?
INVESTOR DEBATE: ROUND I. ARE WE OVER-INDEXING ON PEOPLE & UNDER-INDEXING ON TECH?
WHAT IS THE PRE-SEED PULSE?
Ed Bussey – CEO, Oxford Science Enterprises
Dr Mehmood Khan - CEO, Hevolution Foundation
Ahmed Ismail - Co-founder & COO, Dunia Innovation
Laura Cha, Chairman, HKEX, Welcomes FII PRIORITY in Hong Kong
Impact: What is the Biodiversity Mandate? Powered by HEC Paris FII7
Hope with Tony Robbins FII Priority
DAY3 - Future flash: Lawrence H. Summers
SPECIAL CONVERSATION WITH AN AFRICAN LEADER
CAN TOURISM DRIVE SUSTAINABLE ECONOMIC GROWTH IN AFRICA?
FII INSTITUTE STRATEGIC PARTNER SIGNING CEREMONIES
HOW IS AI IMPROVING HEALTHCARE SYSTEMS?
IS I.T. INFRASTRUCTURE ONE-SIZEFITS-ALL?
Sam Bencheghib - Co-Founder, Sungai Watch
Dr. David Yates - Atmospheric Scientist, National Centre for Atmospheric Science
BITCOIN TOWN HALL
Plenary Session Highlights - Saudi & MENA Insights: What Drives Investment Philiosophies In Emerging Markets
Plenary Session Highlights - Industrial Sovereignty: Can Europe Win The Trade Game?
CAN FINANCIAL INFRASTRUCTURE STILL GO GLOBAL?
FUTURE FLASH: CAN SYSTEMIC READINESS IN CITIES TURN DISRUPTION INTO ADVANTAGE?
CAN AI MAKE MARKETS PERFECTLY EFFICIENT?
FUTURE FLASH: HOW AMBITION AMPLIFIES AFRICA
THE CEO AS NATION-BUILDER
CAN PURPOSE-DRIVEN CAPITAL UNLOCK THE TRILLIONS NEEDED FOR INCLUSIVE GROWTH?
WHAT IS THE PATH TO A THRIVING FRONTIER MARKET?
CAN PUBLIC-PRIVATE COLLABORATION REVOLUTIONIZE DISASTER MANAGEMENT?
CAN HOSPITALITY REMAIN ALL-WEATHER IN A SLOWING ECONOMY?
SAUDI SECTOR SPOTLIGHT ON DEEP-TECH, POWERED BY NTDP
INSIDE THE BATTLE FOR STRATEGIC POWER, WITH DEEP TECH CEOs
Dr. Saifedean Ammous - Best-Selling Author & Economist
How Will the New Asia Redefine the Global Finance? FIIPriority Hong Kong
CAN FINTECH+TRADFI SHOCK-PROOF THE GLOBAL ECONOMY?
WHICH DEEP TECH INVESTMENTS WILL ENABLE A MORE GLOBAL FUTURE?
HOW TO CLOSE THE SERIES B FUNDING GAP IN DEEP/CLIMATE TECH, POWERED BY UP.PARTNERS
Dr. Mohammed Qurban - CEO, National Center for Wildlife, KSA
BREAKIN BARRIERS AND BUILDING MOMENTUM
Plenary Session Highlights - Can Strategic Investment Transform Europe
WHERE ARE THE NEW RETAIL MARKETS FOR PRIVATE CAPITAL?
WILL VERTICAL INTEGRATION DEFINE A NEW AGE OF THE CONGLOMERATE?
3D PRINTING IN THE NEW ERA OF CONSTRUCTION
SAUDI SECTOR SPOTLIGHT ON BANKING, POWERED BY PIF GLOBAL ASSET MANAGEMENT FORUM
CAN BIOENGINEERING SAFEGUARD THE GLOBAL FOOD SUPPLY?
FUTURE FLASH: IS THE NETWORK STATE IMMINENT?
WHAT'S THE PRICE OF SAFETY?
HOW NATION STATES AND NETWORK STATES COOPERATE
INVESTOR DEBATE: ROUND II. DO MEGA FUNDS STIFLE INNOVATION & DIVERSITY IN PRIVATE MARKETS?
THE PLATFORM PARADOX: WHO REALLY WINS IN GIG WORK?
Bruno Maisonnier - CEO & Founder, AnotherBrain
Prof. Yanis Ben Amor - Executive Director, Center for Sustainable Development at the Climate School & Assistant Professor, Columbia University
Hiroaki Kitano - Professor, Okinawa Institute of Science and Technology Graduate School
FUTURE OF GLOBAL ENERGY PART I: VIEW FROM GOVERNMENT
HOW CAN BUSINESSES REACH FINANCIAL TARGETS WHILE CREATING POSITIVE IMPACT?
HOW CAN FINANCIAL LEADERS BUILD A JUST ECONOMY?
M&A INTERVIEW: CRAFTING SUCCESSFUL HEATH-TECH BUSINESS MODELS
EVO OF ALTS: PART II. IS CRYPTO THE FUTURE OF RETAIL INVESTING?
HOW CAN CARBON MARKETS KEEP UP WITH DEMAND?
VENTURE, STUDIOS, PUBLIC/PRIVATE & BEYOND: WHAT ARE THE NEW MODELS OF TRANSFORMATIVE INVESTMENT?
CAN MIAMI REWRITE THE PLAYBOOK FOR 21ST CENTURY URBAN SUCCESS?
HOW ARE NEW FINANCING MODELS RESHAPING THE GEOGRAPHY OF INNOVATION IN EMERGING MARKETS
WHAT IS THE FUTURE OF ENTERTAINMENT
TECHNOLOGY VS JOBS
THE NEXT WAVE OF ARTIFICIAL INTELLIGENCE
IS THE CENTER OF GRAVITY FOR SPORTS SHIFTING TOWARDS SAUDI ARABIA
WHEN VISIONARIES REMAKE THE WORLD FROM A KEYBOARD
FUTURE FLASH: CRACKING THE CODE OF LIVING FOR THE NEXT GENERATION OF MEDICINE
URUGUAY'S dLocal ON REIMAGINING PAYMENT SYSTEMS FOR THE GLOBAL SOUTH
Greg Jackson - CEO & Founder, Octopus Energy
WHICH HEALTHCARE INNOVATIONS WILL SHAPE AFRICA’S FUTURE?
WHAT IS JAPAN'S APPROACH TO BUSINESS AND VENTURE?
SHOULD BANKS PRIORITIZE SOCIAL IMPACT?
IS THIS THE END OF TRADITIONAL MEDIA AS WE KNOW IT
SPORTS - ENTERTAINMENT THE NEXT INVESTMENT BOOM
SAUDI ARABIAS COMPETITIVENESS MODELS
ROBOTICS REVOLUTION
DOES UNCERTAINTY HELP OR HARM REAL ASSET INVESTMENTS?
Members Talk - Nick Carter - CEO & Founder, INGENIOUS.BUILD